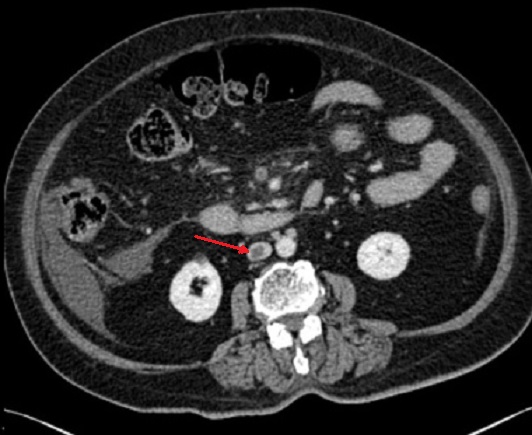

|
-
L'
Ischemie mesenterique : L'ischemie
mesenterique est une urgence de l'abdomen le plus severe et
de plus de meconnue . C'est l' interruption ou
diminution du flux sanguine mesenterique , elle peut etre
arterielle ou veineuse , aigue ou chronique , occlusive ou
non occlusive . En cas de occlusion arterielle aigue ou
chronique , etat de hypoxie tissulaire se presente et lesion
ischemique se developpent , initialement a partir de la
muqueuse et de la sous-muqueuse . Si occlusion se poursuit ,
la necrose devient transmurale et puis gangrene . Il y avait
trois type de ischemie mesenterique : aigue . subaigue et
chronique , et 80% ischemie mesenterique est arteriele et 20% est veineuse .
Clinique est douleur abdominale difuse en 48h ,
vomissement , diarrhe et fiervre sont possible . Exament
laboratoire : Lactate et CRP peut en augemente , acidose
metabolique parfoi en se presence
Techniques radiologiques d'exploration de
ischemie mesenterique est : Technique radiographie TDM
de l'abdomen et pelvienne avec contrast
hydrosoluble intraveineuse . Et les exposes se prendre en
trois phase : Phase non opaque , phase arteriele et phase
veineuse .
Aspect radiologique TDM de ischemie mesenterique
par thrombose arterielle est : En phase aigue image
radiologique est image de fine de la parois ,
infiltration de graisse mesenterique , image aero-mesenterie
. aeroportie et pneumatose parietale de l'intestin et image
de thrombose ảrterielle . En cas subaigue c'est image de
epaissisement de la paroi de l'intestin par oedeme
sous-muqueux et image de sans defaut de rehaussement et stratification
parietale prểserve
Aspect radiologique TDM de ischemie mesenterique
par thrombose veineuse est : image epaissisement de la
paroi de l'intestin , image oedemateuse et aeromesenterie du mesentere et
image de thrombose veineuse .
| |
 |
|
 |
| |
Image radiologique TDM de
ischemie mesenterique arterielle aigue : Image
de dilatation et de fine de paroi de l'intestin .
Aspect de pneunomatose parietale intestinale
est en presence . Coupe TDM axiale |
|
Image aeroportie intra-hepatique
gauche d'une ischemie mesenterique arterielle aigue
. Image TDM en coupe axiale . |
| |
 |
|
 |
| |
Image d'une thombus de artere
mesenterique superieure ( ischemie meresenterique
arterielle aigue ) en TDM phase arterielle ,coupe
sagitale . Sur cette coupe on peut
voyait ảrtere du tronc coeliaque en net et complete
, artere mesenterique superieure est en se voyait
encore d'une partie seul a hyper-dense . Image du
thrombus est iso-dense ( fleche jaune ) . Aspect de
pneumomatose de la paroi de l'intestin est encore se
voyait sur une portion verticale de l'intestin (
fleche rouge ) . Ischemie mesenterique arterielle
aigue en coupe TDM sagitale . |
|
Même cas en coupe
axiale de TDM en phase arterielle . Fleche
rouge est image a íso-dense d'une thrombus de artere
mesenterique superieure . Aspect de fine de la paroi
de l'intestin se voyait encore sur cette coupe . |
| |
 |
|
 |
| |
Ischemie mesenterique
arterielle subaigue de artere mesenterique
superieure : Image de epaissisement de la paroi de
l'intestin ( oedememe sous muqueux a
sans defaut de
rehaussement ) . Image TDM en coupe axiale . |
|
Même cas en coupe TDM
sagitale , phase arterielle : Sur ce coupe on peut
en voyait le thrombus en occluse une part de artere mesenterique superieure ( fleche rouge ) ,
une rachine a inferieure de ảrtere mesenterique
superieure est encore opacifie . Epaissisement avec
sans defaut de rehaussement
de la paroi de l'intestin peut en
voyait a inferieure |
| |
 |
|
 |
| |
- Aspect radiologique de
ischemie mesenterique veineuse de l'intestin : Image
de thrombose d'une partie de la veine mesenterique
superieure et image oedemateuse , aero-mesenterique
du mesentere
en voyait si net ( fleche rouge ) . Aspect de
defaut
de rehaussement de la paroi de l'intestin peut en
voyait . Image radiologique TDM en coupe coronal ,
phase veineuse |
|
Ischemie
mesenterique de l'intestin par thrombose veineuse en
coupe TDM coronale phase veineuse : Image de
thrombus d'une branche de la veine mesenterique
superieure ( fleche rouge ) et aspect de
aereobie-mesenterique de veine mesenterique se
voyait si net ( fleche violet ) et image de
defaut de rehaussement
de la paroi de l'intestin ( fleche jaune ) . |
| |
|
|
|
| |
|
|
 |
| |
Image d'une thrombus de la
veine cave inferieure ( fleche rouge ) et image de
epaissisement a defaut de rehaussement de la paroi
de l'intestin . Ischemie mesenterique veineux de
l'intestin . Image radiologique TDM en coupe axiale
phase veineuse . |
|
Ischemie mesenterique
veineuse de l'intestin par thrombose de veine
mesenterique superieure ( fleche rouge ) et image
d'epaissisement a defaut de rehaussement de la paroi
de l'intestin ( fleche jaune ) . Image radiologique
TDM avec contrast intraveineuse en coupe axiale phase veineuse . |
| |
|
|
|
Traitement : Traitement de ischemie mesenterique
arterielle aigue de l'intestin est resection chirugicale la
portion ischemique . Traitement de ischemie mesenterique de
l'intestin par thombus veineuse est en traitant par
les anticoagulants et 80% se donnent de bons resultats .
Page :
1
/
2
/
3
/
4
/
5
/
6
/
7/
8/9
/
<<
PREVIOUS
<<
RESUME >>
Gs Bui Binh Tho
|
|